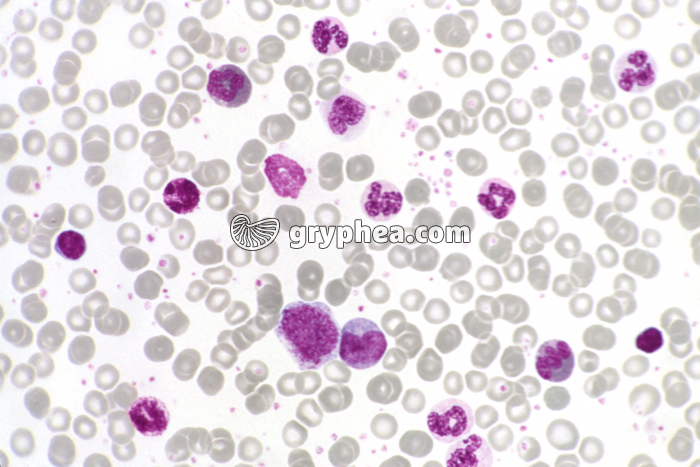
Leucémie aiguë x200 - gryphea.org

Les photographies, infographies, vidéos, sons et textes publiés sur ce site ne sont pas totalement libres de droits. Vous pouvez les utiliser librement à titre personnel, dans la création de vos cours, compte-rendus, diaporamas, en respectant le watermark qui y est inclus, à la condition expresse d'avoir souscrit à un abonnement. Le contrat d’utilisation ne vous autorise cependant pas à diffuser ces documents ailleurs que dans le cadre strict de votre enseignement, et en aucun cas sur les réseaux sociaux. Merci de votre compréhension.
Pour accéder à tous les contenus de gryphea.org, aux photos haute définition et aux vidéos intégrales, profitez de nos offres d'abonnement :
La leucémie correspondent à des cancers de la moelle osseuse, qui se détectent aisément à partir de l’analyse du sang. On classe les leucémies en 4 catégories principales, selon leur vitesse d’évolution et le type de cellules de la moelle osseuse impliquées dans le cancer. Les leucémies d’apparition soudaine sont qualifiées de leucémies aiguës, et dans le cas contraire, de leucémies chroniques. Elles peuvent affecter la lignée lymphoïde (les lymphocytes jeunes ou lymphoblastes sont défaillants) ou celles de la lignée myéloïde (les cellules hématopoïétiques de la moelle osseuse proliférent de façon incontrôlée). Ces leucémies sont alors nomenclaturées en conséquence (LAL, LAM, LLC et LMC).
La suite du commentaire est réservée aux abonnés